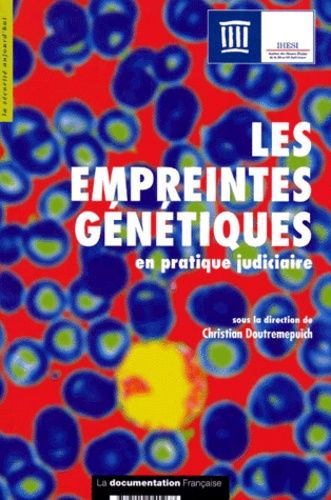
Les Empreintes Génétiques En Pratique Judiciaire

30 résultats
Meilleures ventes
A propos de «Meilleures ventes»
- Format: Non Precisé
Neuf à 27 €
Occasion dès 15 €
Vendez le vôtre
- Collection: GUIDE PRATIQUE
- Format: Beau livre
Neuf à 70 €
Vendez le vôtre
- Collection: Pédagogie Formation
- Format: Broché
1 avis
Neuf à 14,50 €
Occasion dès 6 €
Vendez le vôtre
- Collection: L'oeuvre Et La Psyché
- Format: Broché
Neuf à 26 €
Occasion dès 2,95 €
Vendez le vôtre
- Format: Broché
Neuf à 6,49 €
Occasion dès 3,74 €
Vendez le vôtre
Vendez le vôtre
- Format: Relié
Occasion dès 50 €
Vendez le vôtre
- Format: Broché
Occasion dès 19 €
Vendez le vôtre
- Collection: La Sécurité Aujourd'hui
- Format: Broché
Occasion dès 10,91 €
Vendez le vôtre
- Format: Broché
Occasion dès 55,50 €
Vendez le vôtre
Vendez le vôtre
- Revue
- Spécialités médicales
- Année de parution : 1956
Occasion dès 10 €
Vendez le vôtre
- Format: Broché
Occasion dès 32,80 €
Vendez le vôtre